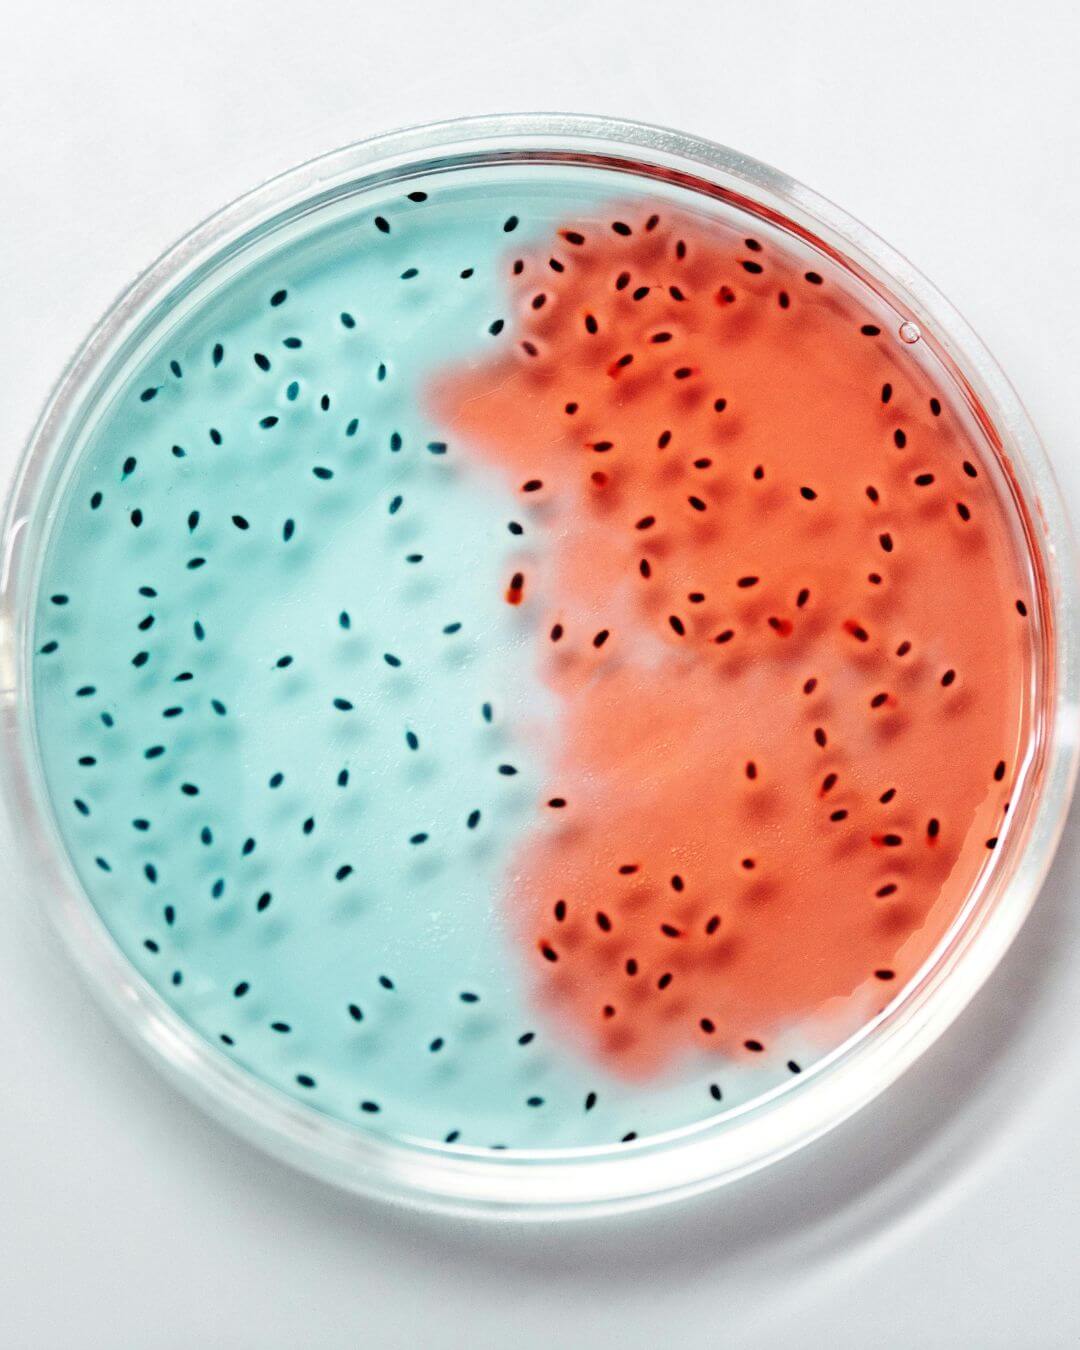
darmflora

Podcastgespräch mit Laura – Teil 3 jetzt auf Spotify anhören
Manchmal beginnt Heilung nicht im Körper, sondern in der Seele.
Wenn Hoffnung aus der Tiefe wächst



Und irgendwann kam der Moment, an dem sie dachte: Ich kann nicht mehr. Doch gerade dort, in dieser Stille, begann etwas Neues. Sie suchte nicht länger nur nach medizinischen Antworten, sondern nach innerer Ruhe, nach einem Weg, wieder Verbindung zu sich selbst zu finden.
Atmen. Fühlen. Loslassen.
Lauras erster Schritt war ungewöhnlich: Hypnose-Therapie. Keine Show-Hypnose, sondern eine sanfte, achtsame Reise nach innen. Zum ersten Mal konnte sie entspannen. Alte Muster, Schuldgefühle und Selbstzweifel zeigten sich und durften gehen.

Dann kam Breathwork dazu, bewusstes Atmen, um festgehaltene Emotionen zu lösen. In einer Session begann sie zu weinen, zu atmen, zu spüren. Und plötzlich war da wieder Hoffnung. Nicht alles war gut, aber etwas in ihr war wieder lebendig.
„Ich bin nicht kaputt“, sagte sie. „Ich bin überfordert. Aber ich bin hier.“
Die Seele darf mit heilen – Psychotherapie als Anker

ihre Angst vor Kontrollverlust

die depressive Verstimmung


Wenn Hormone und Darm zusammen tanzen
Laura lebte schon länger mit PCOS, einer hormonellen Störung, die auch den Blutzucker, die Verdauung und den Zyklus beeinflusst. Und plötzlich ergab vieles Sinn. Doch bevor sie die Hormone anpackte, musste sie erst wieder Stabilität finden, Schritt für Schritt.

Als sich unsere Wege kreuzten
In dieser Phase stieß Laura auf mich und erkannte sich in meiner eigenen Geschichte wieder. Jemand, der versteht, wie es ist, mit einem Magenbypass zu leben. Als wir das erste Mal sprachen, war sofort klar:




Der Blick in den Darm – und was er verriet
Eine Stuhlanalyse brachte schließlich Licht ins Dunkel. Sie zeigte, was Lauras Körper schon lange spürte:

eine Dysbiose (Fehlbesiedlung der Darmflora)

Entzündungszeichen

Pilzbelastung

einen durchlässigen Darm (Leaky Gut)

und ein geschwächtes Immunsystem im Darm
Mit diesen Erkenntnissen konnten wir gezielt beginnen: Sanfte Unterstützung für Leber und Darm, Bitterstoffe, individuell verträgliche Mahlzeiten, achtsame Portionen.
SIBO – die versteckte Ursache
Trotz erster Fortschritte blieb der Bauch gebläht, die Verdauung träge. Ein Atemtest bestätigte: SIBO, eine bakterielle Fehlbesiedlung im Dünndarm. Wir starteten eine angepasste Therapie:



Rückschläge & innere Stärke
Natürlich gab es Tage, an denen das Dumping zurückkam, an denen alles schwer und sinnlos schien. Aber diesmal war sie nicht allein.
Sie hatte ihr Team:




Hoffnung für alle, die sich wiederfinden











